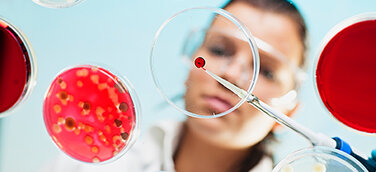
Mikroben, Pilze und Enzyme machen vor, wie biologische Systeme Plastik nicht nur abbauen – sondern in Rohstoffe, Habitate und sogar Medikamente verwandeln.

Die Kling GmbH, Hersteller von aufmerksamkeitsstarken Displays, innovativen Verpackungen und Etuis, hochwertigen Vitrinen, modular aufgebauten Shop-in-Shop-Lösungen, hochwertigen Präsentationskoffer mit Laden, Markenaufsteller sowie angesagten Dekorationen hat nun die Produktion der beliebten X-Press Versandboxen um eine neue, 100 Prozent nachhaltige Variante ergänzt: Die X-Press-Box Ocean-Line.
Es handelt sich hierbei um eine praktische, nahezu unverwüstliche Kleinteileverpackung aus recyceltem Polypropylen, die die Ware auf dem Versandweg schützt. Ein fester Innenrahmen gewährleistet einen sicheren Packraum, während sich der praktische Verschluss immer wieder leicht öffnen und verschließen lässt.
X-Press-Boxen Ocean-Line aus 100 Prozent recyceltem Material
Das eingesetzte Kunststoffgranulat Polypropylen (PP), das Kling für die Herstellung seiner hochwertigen X-Press-Box Ocean-Line verwendet, besteht zu 100 Prozent aus dem Recycling von im Meer befindlichem Plastik. Beim Sammeln und Aufbereiten der Materialien verlässt sich das in Birkenfeld (Schwarzwald) ansässige Unternehmen auf die professionelle Arbeit von Tide Ocean S A.
Bis zum heutigen Tag konnten durch Tide Ocean S A bereits mehr als 30 Millionen Plastikflaschen recycelt werden. Der prozentuale Anteil an neuem Kunststoff in Tide Ocean Material beträgt hierbei (null) 0 Prozent. Darüber hinaus verursacht das tide Upcycling Verfahren bis zu 80 Prozent weniger CO2 Emissionen als die Herstellung von neuem Kunststoff. So leistet Kling einen wertvollen Beitrag zur Wiederverwertung des Kunststoffmülls in den Weltmeeren.
Neben der Verwendung von umweltfreundlichen Materialien und der obligatorischen Trennung von Produktionsabfällen arbeitet Kling aktiv daran, Müll auf ein nötiges Minimum zu reduzieren und die Recyclingquote stetig zu erhöhen.
Auch mit der Übernahme von Baum-Patenschaften leistet die Unternehmensgruppe einen wichtigen Beitrag zum Umweltschutz und Klimaschutz. So produziert das Unternehmen CO2 arm durch eigenen Strom aus Sonnenenergie. Bisher konnten durch die durch die Photovoltaikanlage auf dem Firmengebäude mehr als 640 Tonnen CO2 eingespart werden.
Auch mit Blick in die Zukunft arbeitet das Kling Team daran, dass die Produktionsprozesse am Standort in Birkenfeld bei Pforzheim nahezu klimaneutral werden.
Fakten zur Plastikverschmutzung
Die Plastikverschmutzung ist ein beispielloses Problem, das katastrophale Folgen für eine Vielzahl von Ökosystemen hat. Jedes Jahr werden 10 Millionen Tonnen Plastik in unsere Ozeane gekippt; das entspricht mehr als einer #Lkw Ladung pro Minute.
Mehr über die X-Press-Box Ocean-Line: https://kling.de/de/x-press-box-versandboxen.html
X-Press-Box Ocean-Line online bestellen: https://kling-shop.de/de/80-x-press-box

Kling GmbH
Unternehmen
100 Prozent nachhaltige Versandboxen aus Meeresabfall und Plastikabfall, die X-Press-Box Ocean-Line
Birkenfeld,
Deutschland
Bericht
Die Kling GmbH mit Sitz in Birkenfeld bei Pforzheim gehört seit über 90 Jahren zu den führenden Herstellern im Bereich der verkaufsfördernden Warenpräsentation und ist hierbei auf die Entwicklung von Präsentationsystemen sowie Komplettlösungen für anspruchsvolle Marken und Markenprodukte spezialisiert. Nun hat Kling die Produktion der beliebten X-Press-Versandboxen um eine neue, 100 Prozent nachhaltige Variante ergänzt: Die X-Press-Box Ocean-Line.

Produktneuheit: X-Press-Box Ocean-Line
© Kling GmbH
Branche
Aus Meeres-/Plastikabfall werden 100% nachhaltige Versandboxen
Kontakt
Thematisch passend
Relevanz vor Format: Pressemitteilungen, Journals und Case Studies zum selben Thema.